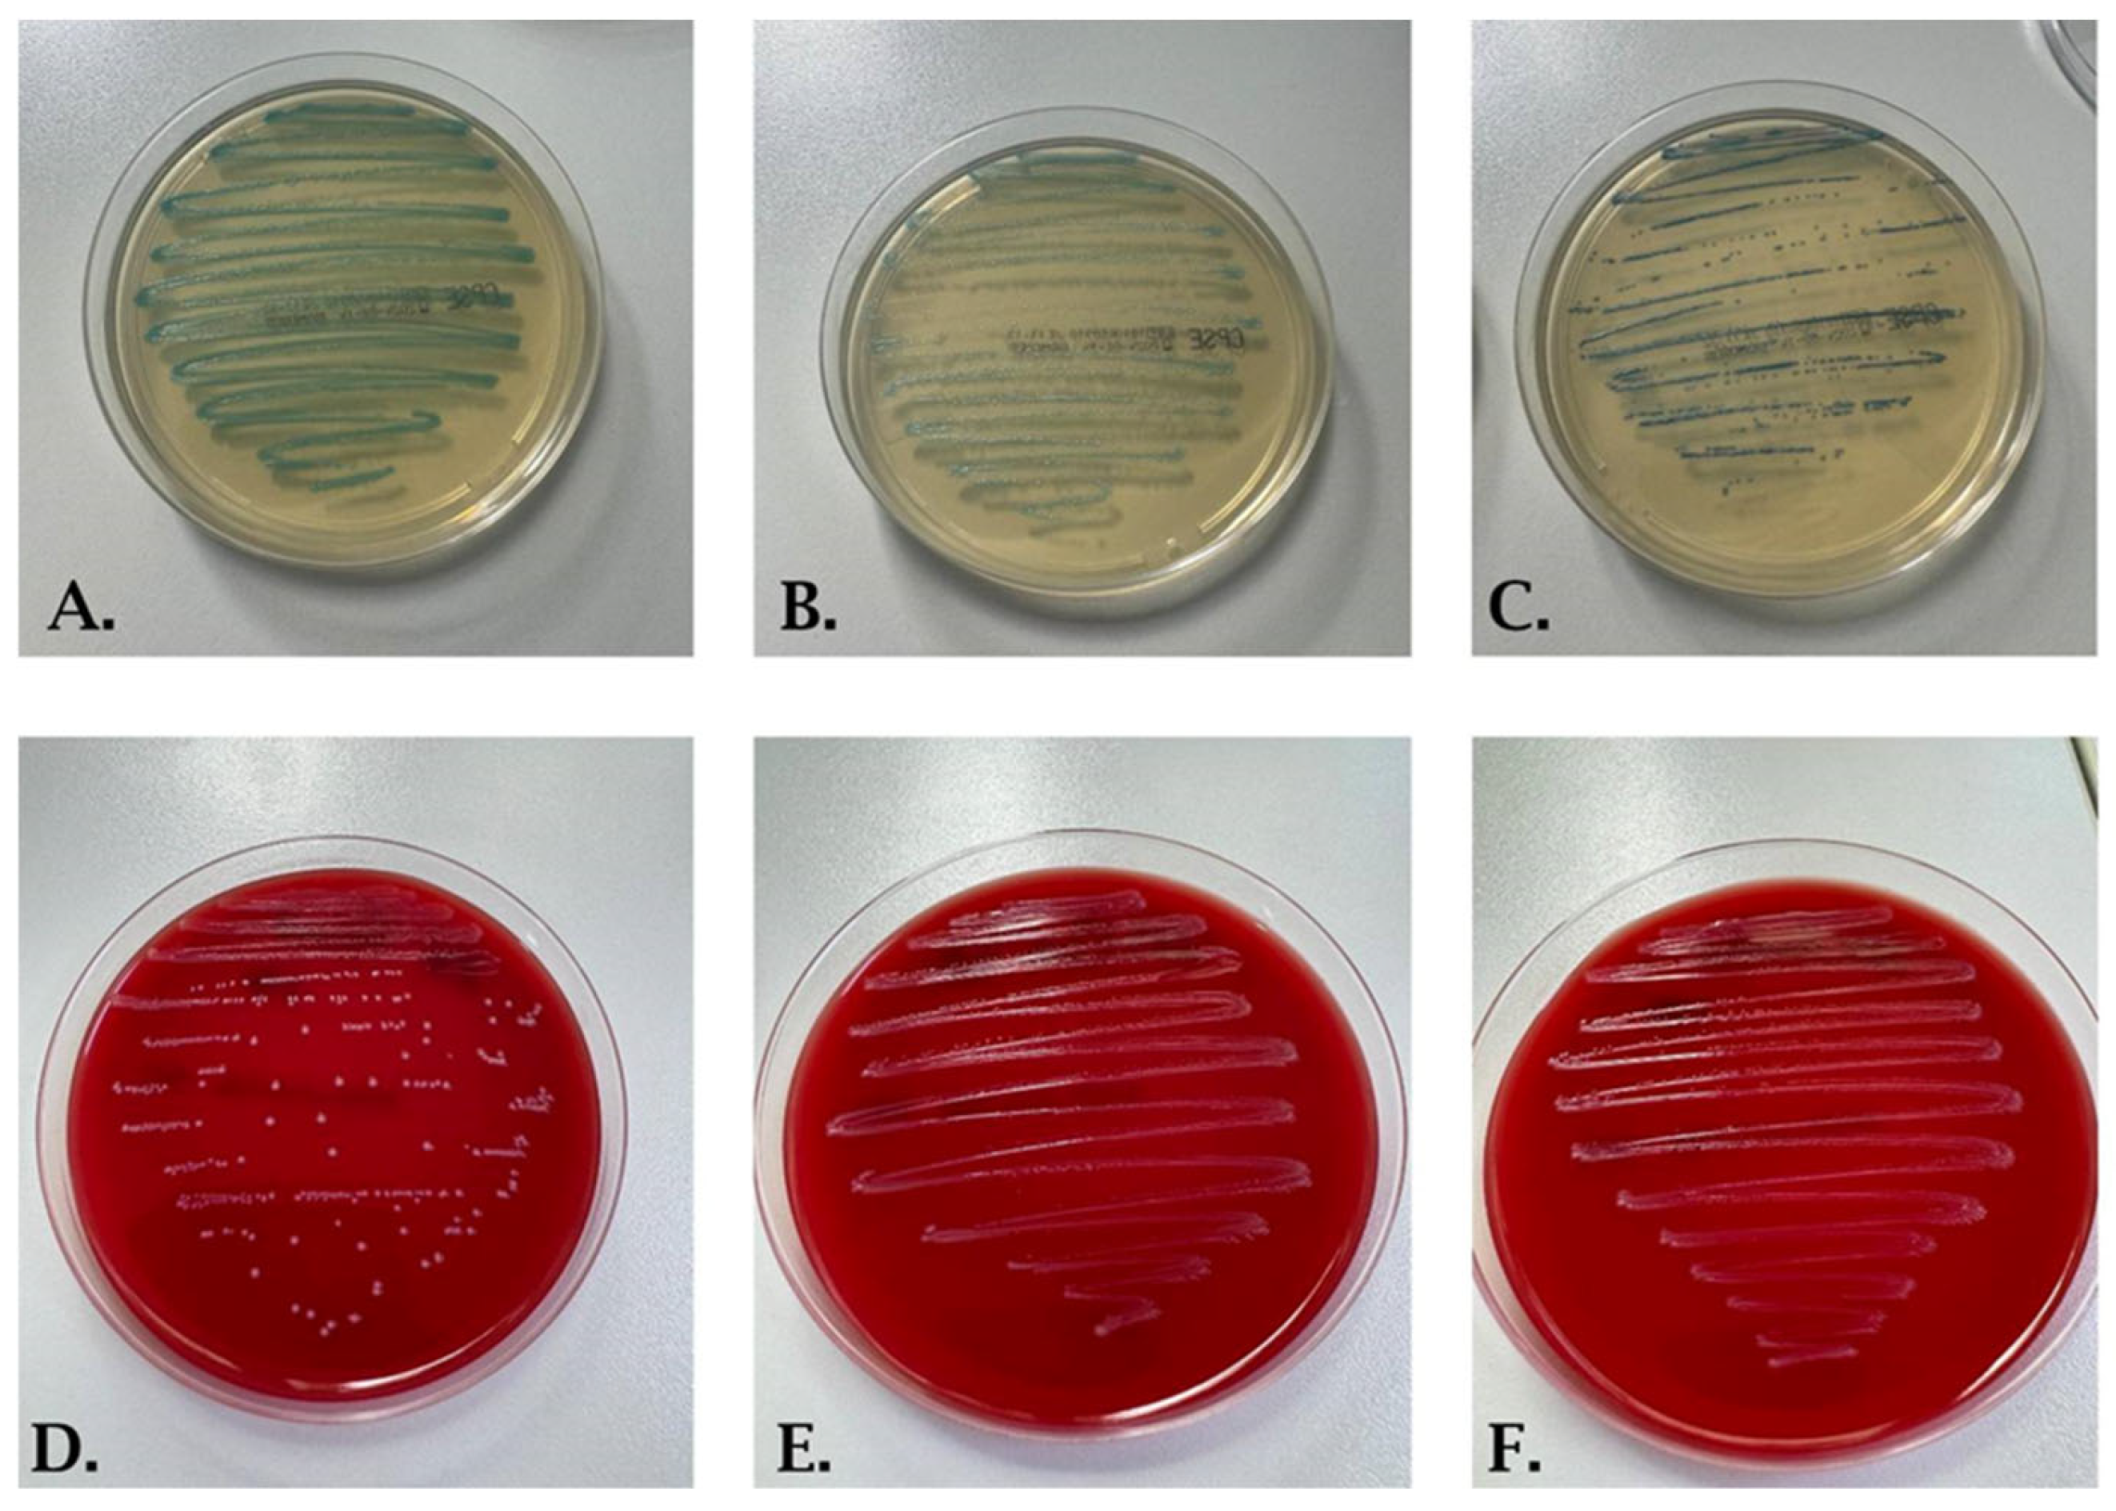

Prevalence and Antibiotic Resistance of Streptococcus agalactiae in Women of Childbearing Age Presenting Urinary Tract Infections from Western Romania
Abstract
1. Introduction
2. Materials and Methods
2.1. Study Design and Setting
2.2. UTI Definition, Sample Collection Inclusion, and Exclusion Criteria
2.3. Microscopic and Bacterial Examination
2.4. Data Collection and Statistical Analysis
2.5. Ethical Approval
3. Results
4. Discussion
5. Conclusions
Author Contributions
Funding
Institutional Review Board Statement
Informed Consent Statement
Data Availability Statement
Conflicts of Interest
References
- Hotchandani, R.; Aggarwal, K. Urinary Tract Infections in Women. Indian J. Clin. Pract. 2012, 23, 187–194. [Google Scholar]
- Pushpalatha, K. Urinary Tract Infection and Management. J. Nighting Nurs. Times 2008, 4, 28–32. [Google Scholar]
- Zhou, Y.; Zhou, Z.; Zheng, L.; Gong, Z.; Li, Y.; Jin, Y.; Huang, Y.; Chi, M. Urinary Tract Infections Caused by Uropathogenic Escherichia coli: Mechanisms of Infection and Treatment Options. Int. J. Mol. Sci. 2023, 24, 10537. [Google Scholar] [CrossRef] [PubMed]
- Saber, S.; Yasmin, N.; Alam, M.T.; Hossain, M.M.; Alam, R.F. Study on Urinary Tract Infection Among Females of Reproductive Age Group in Tertiary Care Teaching Hospital, Dhaka, Bangladesh. Eur. J. Med. Health Sci. 2021, 3, 85–89. [Google Scholar] [CrossRef]
- Hall, J.; Adams, N.H.; Bartlett, L.; Seale, A.C.; Lamagni, T.; Bianchi-Jassir, F.; Lawn, J.E.; Baker, C.J.; Cutland, C.; Heath, P.T.; et al. Maternal Disease with Group B Streptococcus and Serotype Distribution Worldwide: Systematic Review and Meta-Analyses. Clin. Infect. Dis. Off. Publ. Infect. Dis. Soc. Am. 2017, 65, S112–S124. [Google Scholar] [CrossRef]
- Madrid, L.; Seale, A.C.; Kohli-Lynch, M.; Edmond, K.M.; Lawn, J.E.; Heath, P.T.; Madhi, S.A.; Baker, C.J.; Bartlett, L.; Cutland, C.; et al. Infant Group B Streptococcal Disease Incidence and Serotypes Worldwide: Systematic Review and Meta-Analyses. Clin. Infect. Dis. Off. Publ. Infect. Dis. Soc. Am. 2017, 65, S160–S172. [Google Scholar] [CrossRef]
- Liu, Y.; Liu, J. Group B Streptococcus: Virulence Factors and Pathogenic Mechanism. Microorganisms 2022, 10, 2483. [Google Scholar] [CrossRef]
- Kamińska, D.; Ratajczak, M.; Nowak-Malczewska, D.M.; Karolak, J.A.; Kwaśniewski, M.; Szumala-Kakol, A.; Dlugaszewska, J.; Gajecka, M. Macrolide and Lincosamide Resistance of Streptococcus agalactiae in Pregnant Women in Poland. Sci. Rep. 2024, 14, 3877. [Google Scholar] [CrossRef]
- Pantazi, I.; Papafragkos, I.; Kolliniati, O.; Lapi, I.; Tsatsanis, C.; Vergadi, E. Akt Inhibition Promotes Autophagy and Clearance of Group B Streptococcus from the Alveolar Epithelium. Pathogens 2022, 11, 1134. [Google Scholar] [CrossRef]
- Jamrozy, D.; Bijlsma, M.W.; de Goffau, M.C.; van de Beek, D.; Kuijpers, T.W.; Parkhill, J.; van der Ende, A.; Bentley, S.D. Increasing Incidence of Group B Streptococcus Neonatal Infections in the Netherlands Is Associated with Clonal Expansion of CC17 and CC23. Sci. Rep. 2020, 10, 9539. [Google Scholar] [CrossRef]
- Bianchi-Jassir, F.; Paul, P.; To, K.-N.; Carreras-Abad, C.; Seale, A.C.; Jauneikaite, E.; Madhi, S.A.; Russell, N.J.; Hall, J.; Madrid, L.; et al. Systematic Review of Group B Streptococcal Capsular Types, Sequence Types and Surface Proteins as Potential Vaccine Candidates. Vaccine 2020, 38, 6682–6694. [Google Scholar] [CrossRef] [PubMed]
- Lim, S.; Rajagopal, S.; Jeong, Y.R.; Nzegwu, D.; Wright, M.L. Group B Streptococcus and the Vaginal Microbiome among Pregnant Women: A Systematic Review. PeerJ 2021, 9, e11437. [Google Scholar] [CrossRef] [PubMed]
- Maeda, T.; Takayama, Y.; Fujita, T.; Taniyama, D.; Tsuyuki, Y.; Shibayama, A.; Goto, M.; Yoshida, H.; Takahashi, T. Comparison between Invasive and Non-Invasive Streptococcus agalactiae Isolates from Human Adults, Based on Virulence Gene Profiles, Capsular Genotypes, Sequence Types, and Antimicrobial Resistance Patterns. Jpn. J. Infect. Dis. 2021, 74, 316–324. [Google Scholar] [CrossRef] [PubMed]
- Mohanty, S.; Purohit, G.; Rath, S.; Seth, R.K.; Mohanty, R.R. Urinary Tract Infection Due to Group B Streptococcus: A Case Series from Eastern India. Clin. Case Rep. 2021, 9, e04885. [Google Scholar] [CrossRef] [PubMed]
- Beyer, I.; Mergam, A.; Benoit, F.; Theunissen, C.; Pepersack, T. Management of Urinary Tract Infections in the Elderly. Z. Gerontol. Geriatr. 2001, 34, 153–157. [Google Scholar] [CrossRef]
- Edwards, M.S.; Baker, C.J. Group B Streptococcal Infections in Elderly Adults. Clin. Infect. Dis. Off. Publ. Infect. Dis. Soc. Am. 2005, 41, 839–847. [Google Scholar] [CrossRef]
- Kline, K.A.; Lewis, A.L. Gram-Positive Uropathogens, Polymicrobial Urinary Tract Infection, and the Emerging Microbiota of the Urinary Tract. Microbiol. Spectr. 2016, 4, 459–502. [Google Scholar] [CrossRef]
- Elling, R.; Hufnagel, M.; de Zoysa, A.; Lander, F.; Zumstein, K.; Krueger, M.; Henneke, P. Synchronous Recurrence of Group B Streptococcal Late-Onset Sepsis in Twins. Pediatrics 2014, 133, e1388–e1391. [Google Scholar] [CrossRef]
- Kim, H.J.; Kim, S.Y.; Seo, W.H.; Choi, B.M.; Yoo, Y.; Lee, K.H.; Eun, B.L.; Kim, H.J. Outbreak of Late-Onset Group B Streptococcal Infections in Healthy Newborn Infants after Discharge from a Maternity Hospital: A Case Report. J. Korean Med. Sci. 2006, 21, 347–350. [Google Scholar] [CrossRef]
- Nanduri, S.A.; Petit, S.; Smelser, C.; Apostol, M.; Alden, N.B.; Harrison, L.H.; Lynfield, R.; Vagnone, P.S.; Burzlaff, K.; Spina, N.L.; et al. Epidemiology of Invasive Early-Onset and Late-Onset Group B Streptococcal Disease in the United States, 2006 to 2015. JAMA Pediatr. 2019, 173, 224–233. [Google Scholar] [CrossRef]
- Liu, Z.; Jiang, X.; Li, J.; Ji, W.; Zhou, H.; Gong, X.; Miao, B.; Meng, S.; Duan, L.; Shi, Q.; et al. Molecular Characteristics and Antibiotic Resistance Mechanisms of Clindamycin-Resistant Streptococcus agalactiae Isolates in China. Front. Microbiol. 2023, 14, 1138039. [Google Scholar] [CrossRef] [PubMed]
- Schrag, S.J.; Farley, M.M.; Petit, S.; Reingold, A.; Weston, E.J.; Pondo, T.; Hudson Jain, J.; Lynfield, R. Epidemiology of Invasive Early-Onset Neonatal Sepsis, 2005 to 2014. Pediatrics 2016, 138, e20162013. [Google Scholar] [CrossRef] [PubMed]
- Zhu, Y.; Huang, J.; Lin, X.-Z.; Chen, C. Group B Streptococcus Colonization in Late Pregnancy and Invasive Infection in Neonates in China: A Population-Based 3-Year Study. Neonatology 2019, 115, 301–309. [Google Scholar] [CrossRef] [PubMed]
- Hanna, M.; Noor, A. Streptococcus Group B. In StatPearls; StatPearls Publishing: Treasure Island, FL, USA, 2024. [Google Scholar]
- Berardi, A.; Rossi, C.; Lugli, L.; Creti, R.; Bacchi Reggiani, M.L.; Lanari, M.; Memo, L.; Pedna, M.F.; Venturelli, C.; Perrone, E.; et al. Group B Streptococcus Late-Onset Disease: 2003–2010. Pediatrics 2013, 131, e361–e368. [Google Scholar] [CrossRef] [PubMed]
- Creti, R.; Imperi, M.; Berardi, A.; Lindh, E.; Alfarone, G.; Pataracchia, M.; Recchia, S.; The Italian Network on Neonatal and Infant Gbs Infections. Invasive Group B Streptococcal Disease in Neonates and Infants, Italy, Years 2015–2019. Microorganisms 2021, 9, 2579. [Google Scholar] [CrossRef]
- Berardi, A.; Rossi, C.; Creti, R.; China, M.; Gherardi, G.; Venturelli, C.; Rumpianesi, F.; Ferrari, F. Group B Streptococcal Colonization in 160 Mother-Baby Pairs: A Prospective Cohort Study. J. Pediatr. 2013, 163, 1099–1104.e1. [Google Scholar] [CrossRef]
- Menichini, D.; Chiossi, G.; Monari, F.; De Seta, F.; Facchinetti, F. Supplementation of Probiotics in Pregnant Women Targeting Group B Streptococcus Colonization: A Systematic Review and Meta-Analysis. Nutrients 2022, 14, 4520. [Google Scholar] [CrossRef]
- ACOG. Prevention of Group B Streptococcal Early-Onset Disease in Newborns: ACOG Committee Opinion, Number 782. Obstet. Gynecol. 2019, 134, 1. [Google Scholar] [CrossRef]
- Sahuquillo-Arce, J.M.; Hernández-Cabezas, A.; Castaño-Aroca, M.J.; Chouman-Arcas, R.; Díaz-Aguirre, E.; Acosta-Boga, B.; López-Hontangas, J.L. Streptococcus agalactiae in Childbearing Age Immigrant Women in Comunitat Valenciana (Spain). Sci. Rep. 2020, 10, 9904. [Google Scholar] [CrossRef]
- Filkins, L.; Hauser, J.R.; Robinson-Dunn, B.; Tibbetts, R.; Boyanton, B.L.; Revell, P. American Society for Microbiology Provides 2020 Guidelines for Detection and Identification of Group B Streptococcus. J. Clin. Microbiol. 2020, 59, e01230-20. [Google Scholar] [CrossRef]
- Verani, J.R.; McGee, L.; Schrag, S.J.; Division of Bacterial Diseases, National Center for Immunization and Respiratory Diseases, Centers for Disease Control and Prevention (CDC). Prevention of Perinatal Group B Streptococcal Disease—Revised Guidelines from CDC, 2010. MMWR Recomm. Rep. Morb. Mortal. Wkly. Rep. Recomm. Rep. 2010, 59, 1–36. [Google Scholar]
- Recensământul Populației Și Locuințelor, Runda 2021. Comunicat de Presă. Institutul Național de Statistică. Available online: https://Ar.Prefectura.Mai.Gov.Ro/Wp-Content/Uploads/Sites/13/2023/01/Comunicat-de-Presa-Statistica.Pdf (accessed on 18 February 2024).
- BioMérieux. VITEK® 2 GP Card for Gram-Positive Bacteria Identification; Technical Manual; BioMérieux, Inc.: Marcy-l’Étoile, France, 2023; Available online: https://www.biomerieux.com (accessed on 10 September 2024).
- The European Committee on Antimicrobial Susceptibility Testing (EUCAST). Breakpoint Tables for Interpretation of MICs and Zone Diameters, Version 13.0 [Internet]. 2023. Available online: http://www.eucast.org (accessed on 10 September 2024).
- Gonçalves, B.P.; Procter, S.R.; Paul, P.; Chandna, J.; Lewin, A.; Seedat, F.; Koukounari, A.; Dangor, Z.; Leahy, S.; Santhanam, S.; et al. Group B Streptococcus Infection during Pregnancy and Infancy: Estimates of Regional and Global Burden. Lancet Glob. Health 2022, 10, e807–e819. [Google Scholar] [CrossRef] [PubMed]
- Heath, P.T.; Schuchat, A. Perinatal Group B Streptococcal Disease. Best Pract. Res. Clin. Obstet. Gynaecol. 2007, 21, 411–424. [Google Scholar] [CrossRef] [PubMed]
- Le Doare, K.; Heath, P.T. An Overview of Global GBS Epidemiology. Vaccine 2013, 31 (Suppl. S4), D7–D12. [Google Scholar] [CrossRef]
- Schuchat, A. Epidemiology of Group B Streptococcal Disease in the United States: Shifting Paradigms. Clin. Microbiol. Rev. 1998, 11, 497–513. [Google Scholar] [CrossRef]
- Seale, A.C.; Bianchi-Jassir, F.; Russell, N.J.; Kohli-Lynch, M.; Tann, C.J.; Hall, J.; Madrid, L.; Blencowe, H.; Cousens, S.; Baker, C.J.; et al. Estimates of the Burden of Group B Streptococcal Disease Worldwide for Pregnant Women, Stillbirths, and Children. Clin. Infect. Dis. Off. Publ. Infect. Dis. Soc. Am. 2017, 65, S200–S219. [Google Scholar] [CrossRef]
- Ramos, B.d.A.; Kanninen, T.T.; Sisti, G.; Witkin, S.S. Microorganisms in the Female Genital Tract during Pregnancy: Tolerance versus Pathogenesis. Am. J. Reprod. Immunol. 2015, 73, 383–389. [Google Scholar] [CrossRef]
- Brokaw, A.; Furuta, A.; Dacanay, M.; Rajagopal, L.; Adams Waldorf, K.M. Bacterial and Host Determinants of Group B Streptococcal Vaginal Colonization and Ascending Infection in Pregnancy. Front. Cell. Infect. Microbiol. 2021, 11, 720789. [Google Scholar] [CrossRef]
- Patras, K.A.; Nizet, V. Group B Streptococcal Maternal Colonization and Neonatal Disease: Molecular Mechanisms and Preventative Approaches. Front. Pediatr. 2018, 6, 27. [Google Scholar] [CrossRef]
- Shabayek, S.; Abdellah, A.M.; Salah, M.; Ramadan, M.; Fahmy, N. Alterations of the Vaginal Microbiome in Healthy Pregnant Women Positive for Group B Streptococcus Colonization during the Third Trimester. BMC Microbiol. 2022, 22, 313. [Google Scholar] [CrossRef]
- Santi, I.; Grifantini, R.; Jiang, S.-M.; Brettoni, C.; Grandi, G.; Wessels, M.R.; Soriani, M. CsrRS Regulates Group B Streptococcus Virulence Gene Expression in Response to Environmental pH: A New Perspective on Vaccine Development. J. Bacteriol. 2009, 191, 5387–5397. [Google Scholar] [CrossRef] [PubMed]
- Vornhagen, J.; Adams Waldorf, K.M.; Rajagopal, L. Perinatal Group B Streptococcal Infections: Virulence Factors, Immunity, and Prevention Strategies. Trends Microbiol. 2017, 25, 919–931. [Google Scholar] [CrossRef] [PubMed]
- Armistead, B.; Oler, E.; Adams Waldorf, K.; Rajagopal, L. The Double Life of Group B Streptococcus: Asymptomatic Colonizer and Potent Pathogen. J. Mol. Biol. 2019, 431, 2914–2931. [Google Scholar] [CrossRef] [PubMed]
- Ferrieri, P.; Blair, L.L. Pharyngeal Carriage of Group B Streptococci: Detection by Three Methods. J. Clin. Microbiol. 1977, 6, 136–139. [Google Scholar] [CrossRef] [PubMed]
- van der Mee-Marquet, N.; Fourny, L.; Arnault, L.; Domelier, A.-S.; Salloum, M.; Lartigue, M.-F.; Quentin, R. Molecular Characterization of Human-Colonizing Streptococcus agalactiae Strains Isolated from Throat, Skin, Anal Margin, and Genital Body Sites. J. Clin. Microbiol. 2008, 46, 2906–2911. [Google Scholar] [CrossRef]
- Dadi, B.R.; Sime, M.; Seid, M.; Tadesse, D.; Siraj, M.; Alelign, D.; Solomon, Z. Vertical Transmission, Risk Factors, and Antimicrobial Resistance Patterns of Group B Streptococcus among Mothers and Their Neonates in Southern Ethiopia. Can. J. Infect. Dis. Med. Microbiol. J. Can. Mal. Infect. Microbiol. Medicale 2022, 2022, 8163396. [Google Scholar] [CrossRef]
- Hughes, R.; Brocklehurst, P.; Steer, P.; Heath, P.; Stenson, B. Gynaecologists on Behalf of the Royal College of Obstetricians and Gynaecologists. Prevention of Early-Onset Neonatal Group B Streptococcal Disease: Green-Top Guideline No. 36. BJOG 2017, 124, e280–e305. [Google Scholar] [CrossRef]
- Liang, B.; Chen, H.; Yu, D.; Zhao, W.; Cai, X.; Qiu, H.; Xu, L. Molecular Epidemiology of Group B Streptococcus Isolates from Pregnant Women with Premature Rupture of Membranes in Fuzhou, China. Infect. Drug Resist. 2023, 16, 269–278. [Google Scholar] [CrossRef]
- Melin, P.; Efstratiou, A. Group B Streptococcal Epidemiology and Vaccine Needs in Developed Countries. Vaccine 2013, 31 (Suppl. S4), D31–D42. [Google Scholar] [CrossRef]
- Chu, Y.W.; Tse, C.; Tsang, G.K.-L.; So, D.K.-S.; Fung, J.T.-L.; Lo, J.Y.-C. Invasive Group B Streptococcus Isolates Showing Reduced Susceptibility to Penicillin in Hong Kong. J. Antimicrob. Chemother. 2007, 60, 1407–1409. [Google Scholar] [CrossRef]
- Kimura, K.; Suzuki, S.; Wachino, J.; Kurokawa, H.; Yamane, K.; Shibata, N.; Nagano, N.; Kato, H.; Shibayama, K.; Arakawa, Y. First Molecular Characterization of Group B Streptococci with Reduced Penicillin Susceptibility. Antimicrob. Agents Chemother. 2008, 52, 2890–2897. [Google Scholar] [CrossRef] [PubMed]
- Nagano, N.; Nagano, Y.; Toyama, M.; Kimura, K.; Tamura, T.; Shibayama, K.; Arakawa, Y. Nosocomial Spread of Multidrug-Resistant Group B Streptococci with Reduced Penicillin Susceptibility Belonging to Clonal Complex 1. J. Antimicrob. Chemother. 2012, 67, 849–856. [Google Scholar] [CrossRef] [PubMed]
- Dahesh, S.; Hensler, M.E.; Van Sorge, N.M.; Gertz, R.E.; Schrag, S.; Nizet, V.; Beall, B.W. Point Mutation in the Group B Streptococcal Pbp2x Gene Conferring Decreased Susceptibility to Beta-Lactam Antibiotics. Antimicrob. Agents Chemother. 2008, 52, 2915–2918. [Google Scholar] [CrossRef] [PubMed]
- Yi, A.; Kim, C.-K.; Kimura, K.; Arakawa, Y.; Hur, M.; Yun, Y.-M.; Moon, H.-W. First Case in Korea of Group B Streptococcus with Reduced Penicillin Susceptibility Harboring Amino Acid Substitutions in Penicillin-Binding Protein 2X. Ann. Lab. Med. 2019, 39, 414–416. [Google Scholar] [CrossRef] [PubMed]
- Hayes, K.; O’Halloran, F.; Cotter, L. A Review of Antibiotic Resistance in Group B Streptococcus: The Story so Far. Crit. Rev. Microbiol. 2020, 46, 253–269. [Google Scholar] [CrossRef]
- Miller, E.L. The Penicillins: A Review and Update. J. Midwifery Womens Health 2002, 47, 426–434. [Google Scholar] [CrossRef]
- Kumalo, A.; Gebre, B.; Shiferaw, S.; Wolde, W.; Shonde, T. Group B Streptococci Recto-Vaginal Colonization, Antimicrobial Susceptibility Pattern, and Associated Factors among Pregnant Women at Selected Health Facilities of Wolaita Sodo Town, Southern Ethiopia. Front. Microbiol. 2023, 14, 1277928. [Google Scholar] [CrossRef]
- Mudzana, R.; Mavenyengwa, R.T.; Gudza-Mugabe, M. Analysis of Virulence Factors and Antibiotic Resistance Genes in Group B Streptococcus from Clinical Samples. BMC Infect. Dis. 2021, 21, 125. [Google Scholar] [CrossRef]
- Bolukaoto, J.Y.; Monyama, C.M.; Chukwu, M.O.; Lekala, S.M.; Nchabeleng, M.; Maloba, M.R.B.; Mavenyengwa, R.T.; Lebelo, S.L.; Monokoane, S.T.; Tshepuwane, C.; et al. Antibiotic Resistance of Streptococcus agalactiae Isolated from Pregnant Women in Garankuwa, South Africa. BMC Res. Notes 2015, 8, 364. [Google Scholar] [CrossRef]
- Zakerifar, M.; Kaboosi, H.; Goli, H.R.; Rahmani, Z.; Peyravii Ghadikolaii, F. Antibiotic Resistance Genes and Molecular Typing of Streptococcus agalactiae Isolated from Pregnant Women. BMC Pregnancy Childbirth 2023, 23, 43. [Google Scholar] [CrossRef]
- Lopes, E.; Fernandes, T.; Machado, M.P.; Carriço, J.A.; Melo-Cristino, J.; Ramirez, M.; Martins, E.R.; Portuguese Group for the Study of Streptococcal Infections. Increasing Macrolide Resistance among Streptococcus agalactiae Causing Invasive Disease in Non-Pregnant Adults Was Driven by a Single Capsular-Transformed Lineage, Portugal, 2009 to 2015. Eurosurveillance 2018, 23, 1700473. [Google Scholar] [CrossRef] [PubMed]
- Bergal, A.; Loucif, L.; Benouareth, D.E.; Bentorki, A.A.; Abat, C.; Rolain, J.-M. Molecular Epidemiology and Distribution of Serotypes, Genotypes, and Antibiotic Resistance Genes of Streptococcus agalactiae Clinical Isolates from Guelma, Algeria and Marseille, France. Eur. J. Clin. Microbiol. Infect. Dis. Off. Publ. Eur. Soc. Clin. Microbiol. 2015, 34, 2339–2348. [Google Scholar] [CrossRef] [PubMed]
- Matani, C.; Trezzi, M.; Matteini, A.; Catalani, C.; Messeri, D.; Catalani, C. Streptococcus agalactiae: Prevalence of Antimicrobial Resistance in Vaginal and Rectal Swabs in Italian Pregnant Women. Infez. Med. 2016, 24, 217–221. [Google Scholar] [PubMed]
- Capanna, F.; Emonet, S.P.; Cherkaoui, A.; Irion, O.; Schrenzel, J.; Martinez de Tejada, B. Antibiotic Resistance Patterns among Group B Streptococcus Isolates: Implications for Antibiotic Prophylaxis for Early-Onset Neonatal Sepsis. Swiss Med. Wkly. 2013, 143, w13778. [Google Scholar] [CrossRef] [PubMed]
- Petca, A.; Șandru, F.; Negoiță, S.; Dumitrașcu, M.C.; Dimcea, D.A.-M.; Nedelcu, T.; Mehedințu, C.; Filipov, M.M.; Petca, R.-C. Antimicrobial Resistance Profile of Group B Streptococci Colonization in a Sample Population of Pregnant Women from Romania. Microorganisms 2024, 12, 414. [Google Scholar] [CrossRef]
- Dilrukshi, N.; Kottahachchi, J.; Dissanayake, T.; Fernando, N. Antibiotic Sensitivity of Group B Streptococcus from Pregnant Mothers and Its Association with Resistance Genes. Med. Princ. Pract. Int. J. Kuwait Univ. Health Sci. Cent. 2023, 32, 126–132. [Google Scholar] [CrossRef]
- Lu, B.; Chen, X.; Wang, J.; Wang, D.; Zeng, J.; Li, Y.; Li, D.; Zhu, F.; Cui, Y.; Huang, L. Molecular Characteristics and Antimicrobial Resistance in Invasive and Noninvasive Group B Streptococcus between 2008 and 2015 in China. Diagn. Microbiol. Infect. Dis. 2016, 86, 351–357. [Google Scholar] [CrossRef]
- Wang, P.; Tong, J.; Ma, X.; Song, F.; Fan, L.; Guo, C.; Shi, W.; Yu, S.; Yao, K.; Yang, Y. Serotypes, Antibiotic Susceptibilities, and Multi-Locus Sequence Type Profiles of Streptococcus agalactiae Isolates Circulating in Beijing, China. PLoS ONE 2015, 10, e0120035. [Google Scholar] [CrossRef]
- Van Du, V.; Dung, P.T.; Toan, N.L.; Van Mao, C.; Bac, N.T.; Van Tong, H.; Son, H.A.; Thuan, N.D.; Viet, N.T. Antimicrobial Resistance in Colonizing Group B Streptococcus among Pregnant Women from a Hospital in Vietnam. Sci. Rep. 2021, 11, 20845. [Google Scholar] [CrossRef]
- Dashtizade, M.; Zolfaghari, M.R.; Yousefi, M.; Nazari-Alam, A. Antibiotic Susceptibility Patterns and Prevalence of Streptococcus agalactiae Rectovaginal Colonization Among Pregnant Women in Iran. Rev. Bras. Ginecol. E Obstet. Rev. Fed. Bras. Soc. Ginecol. E Obstet. 2020, 42, 454–459. [Google Scholar] [CrossRef]
- Kao, Y.; Tsai, M.-H.; Lai, M.-Y.; Chu, S.-M.; Huang, H.-R.; Chiang, M.-C.; Fu, R.-H.; Lu, J.-J.; Hsu, J.-F. Emerging Serotype III Sequence Type 17 Group B Streptococcus Invasive Infection in Infants: The Clinical Characteristics and Impacts on Outcomes. BMC Infect. Dis. 2019, 19, 538. [Google Scholar] [CrossRef] [PubMed]
- Onipede, A.; Adefusi, O.; Adeyemi, A.; Adejuyigbe, E.; Oyelese, A.; Ogunniyi, T. Group B Streptococcus Carriage during Late Pregnancy in Ile-Ife, Nigeria. Afr. J. Clin. Exp. Microbiol. 2012, 13, 135–143. [Google Scholar] [CrossRef][Green Version]
- Ngom, N.S.; Gassama, O.; Dieng, A.; Diakhaby, E.B.; Ndiaye, S.M.L.; Tine, A.; Karam, F.; Lo, G.; Ba-Diallo, A.; Boye, C.S.B.; et al. Vaginal Carriage of Group B Streptococcus (GBS) in Pregnant Women, Antibiotic Sensitivity and Associated Risk Factors in Dakar, Senegal. Microbiol. Insights 2023, 16, 11786361231174419. [Google Scholar] [CrossRef] [PubMed]
- Armillei, M.K.; Lomakin, I.B.; Del Rosso, J.Q.; Grada, A.; Bunick, C.G. Scientific Rationale and Clinical Basis for Clindamycin Use in the Treatment of Dermatologic Disease. Antibiotics 2024, 13, 270. [Google Scholar] [CrossRef]
- ACOG. Prevention of Group B Streptococcal Early-Onset Disease in Newborns: ACOG Committee Opinion, Number 797. Obstet. Gynecol. 2020, 135, e51–e72. [Google Scholar] [CrossRef]
- Jisuvei, S.C.; Osoti, A.; Njeri, M.A. Prevalence, Antimicrobial Susceptibility Patterns, Serotypes and Risk Factors for Group B Streptococcus Rectovaginal Isolates among Pregnant Women at Kenyatta National Hospital, Kenya; a Cross-Sectional Study. BMC Infect. Dis. 2020, 20, 302. [Google Scholar] [CrossRef]
- Assefa, S.; Desta, K.; Lema, T. Group B Streptococci Vaginal Colonization and Drug Susceptibility Pattern among Pregnant Women Attending in Selected Public Antenatal Care Centers in Addis Ababa, Ethiopia. BMC Pregnancy Childbirth 2018, 18, 135. [Google Scholar] [CrossRef]
- Scheld, W.M. Maintaining Fluoroquinolone Class Efficacy: Review of Influencing Factors. Emerg. Infect. Dis. 2003, 9, 1–9. [Google Scholar] [CrossRef]
- Zheng, J.-X.; Chen, Z.; Xu, Z.-C.; Chen, J.-W.; Xu, G.-J.; Sun, X.; Yu, Z.-J.; Qu, D. In Vitro Evaluation of the Antibacterial Activities of Radezolid and Linezolid for Streptococcus agalactiae. Microb. Pathog. 2020, 139, 103866. [Google Scholar] [CrossRef]
- Mühlberg, E.; Umstätter, F.; Kleist, C.; Domhan, C.; Mier, W.; Uhl, P. Renaissance of Vancomycin: Approaches for Breaking Antibiotic Resistance in Multidrug-Resistant Bacteria. Can. J. Microbiol. 2020, 66, 11–16. [Google Scholar] [CrossRef]
- Park, C.; Nichols, M.; Schrag, S.J. Two Cases of Invasive Vancomycin-Resistant Group B Streptococcus Infection. N. Engl. J. Med. 2014, 370, 885–886. [Google Scholar] [CrossRef] [PubMed]
- Gizachew, M.; Tiruneh, M.; Moges, F.; Tessema, B. Streptococcus agalactiae Maternal Colonization, Antibiotic Resistance and Serotype Profiles in Africa: A Meta-Analysis. Ann. Clin. Microbiol. Antimicrob. 2019, 18, 14. [Google Scholar] [CrossRef] [PubMed]
- Chopra, I.; Roberts, M. Tetracycline Antibiotics: Mode of Action, Applications, Molecular Biology, and Epidemiology of Bacterial Resistance. Microbiol. Mol. Biol. Rev. 2001, 65, 232–260. [Google Scholar] [CrossRef] [PubMed]
- Hays, C.; Louis, M.; Plainvert, C.; Dmytruk, N.; Touak, G.; Trieu-Cuot, P.; Poyart, C.; Tazi, A. Changing Epidemiology of Group B Streptococcus Susceptibility to Fluoroquinolones and Aminoglycosides in France. Antimicrob. Agents Chemother. 2016, 60, 7424–7430. [Google Scholar] [CrossRef]
- Lamagni, T.L.; Keshishian, C.; Efstratiou, A.; Guy, R.; Henderson, K.L.; Broughton, K.; Sheridan, E. Emerging Trends in the Epidemiology of Invasive Group B Streptococcal Disease in England and Wales, 1991–2010. Clin. Infect. Dis. Off. Publ. Infect. Dis. Soc. Am. 2013, 57, 682–688. [Google Scholar] [CrossRef]
- Metcalf, B.J.; Chochua, S.; Gertz, R.E.; Hawkins, P.A.; Ricaldi, J.; Li, Z.; Walker, H.; Tran, T.; Rivers, J.; Mathis, S.; et al. Short-Read Whole Genome Sequencing for Determination of Antimicrobial Resistance Mechanisms and Capsular Serotypes of Current Invasive Streptococcus agalactiae Recovered in the USA. Clin. Microbiol. Infect. Off. Publ. Eur. Soc. Clin. Microbiol. Infect. Dis. 2017, 23, 574.e7–574.e14. [Google Scholar] [CrossRef]
- Yaghoubi, S.; Zekiy, A.O.; Krutova, M.; Gholami, M.; Kouhsari, E.; Sholeh, M.; Ghafouri, Z.; Maleki, F. Tigecycline Antibacterial Activity, Clinical Effectiveness, and Mechanisms and Epidemiology of Resistance: Narrative Review. Eur. J. Clin. Microbiol. Infect. Dis. 2022, 41, 1003–1022. [Google Scholar] [CrossRef]
- Betriu, C.; Culebras, E.; Rodríguez-Avial, I.; Gómez, M.; Sánchez, B.A.; Picazo, J.J. In Vitro Activities of Tigecycline against Erythromycin-Resistant Streptococcus pyogenes and Streptococcus agalactiae: Mechanisms of Macrolide and Tetracycline Resistance. Antimicrob. Agents Chemother. 2004, 48, 323–325. [Google Scholar] [CrossRef]
- Sorlozano, A.; Gutierrez, J.; Roman, E.; de Dios Luna, J.; Roman, J.; Liebana, J.; Piedrola, G. A Comparison of the Activity of Tigecycline against Multiresistant Clinical Isolates of Staphylococcus aureus and Streptococcus agalactiae. Diagn. Microbiol. Infect. Dis. 2007, 58, 487–489. [Google Scholar] [CrossRef]
- Gong, X.; Jin, Y.; Han, X.; Jiang, X.; Miao, B.; Meng, S.; Zhang, J.; Zhou, H.; Zheng, H.; Feng, J.; et al. Genomic Characterization and Resistance Features of Streptococcus agalactiae Isolated from Non-Pregnant Adults in Shandong, China. J. Glob. Antimicrob. Resist. 2024, 38, 146–153. [Google Scholar] [CrossRef]
- Soares, G.C.T.; Alviano, D.S.; da Silva Santos, G.; Alviano, C.S.; Mattos-Guaraldi, A.L.; Nagao, P.E. Prevalence of Group B Streptococcus Serotypes III and V in Pregnant Women of Rio de Janeiro, Brazil. Braz. J. Microbiol. Publ. Braz. Soc. Microbiol. 2013, 44, 869–872. [Google Scholar] [CrossRef] [PubMed]

| Age Group (%) | Females Infected with Streptococcus agalactiae (n = 130) (%) | Healthy Females (n = 14,501) (%) | cOR | 95% CI | p-Value |
|---|---|---|---|---|---|
| 18–24 years (100) | 13 (0.63) | 2052 (99.37) | Ref. | ||
| 25–34 years (100) | 90 (2.20) | 7431 (98.90) | 1.91 | 1.07–3.43 | 0.03 |
| 34–45 years (100) | 27 (0.54) | 5018 (99.46) | 0.85 | 0.44–1.65 | 0.63 |
| Area of residence (%) | |||||
| Rural (100) | 37 (0.91) | 4014 (99.09) | Ref. | ||
| Urban (100) | 93 (0.88) | 10,487 (99.12) | 0.96 | 0.66–1.41 | 0.84 |
| Antibiotic (Total, 100%) | Sensible (%) | Intermediate (%) | Resistant (%) |
|---|---|---|---|
| Penicillin (n = 130) | 130 (100%) | 0 (0%) | 0 (0%) |
| Ampicillin (n = 88) | 88 (100%) | 0 (0%) | 0 (0%) |
| Levofloxacin (n = 40) | 0 (0%) | 36 (90%) | 4 (10%) |
| Moxifloxacin (n = 130) | 123 (94.62%) | 0 (0%) | 7 (5.38%) |
| Erythromycin (n = 40) | 26 (65%) | 0 (0%) | 14 (35%) |
| Clindamycin (n = 128) | 29 (22.66%) | 0 (0%) | 99 (77.34%) |
| Linezolid (n = 127) | 127 (100%) | 0 (0%) | 0 (0%) |
| Teicoplanin (n = 69) | 69 (100%) | 0 (0%) | 0 (0%) |
| Vancomycin (n = 122) | 122 (100%) | 0 (0%) | 0 (0%) |
| Tetracycline (n = 130) | 15 (11.54%) | 0 (0%) | 115 (88.46%) |
| Tigecycline (n = 122) | 122 (100%) | 0 (0%) | 0 (0%) |
| Chloramphenicol (n = 39) | 38 (97.44%) | 0 (0%) | 1 (2.56%) |
| Rifampicin (n = 39) | 21 (53.85%) | 18 (46.15%) | 0 (0%) |
| Trimethoprim + sulfamethoxazole (n = 130) | 130 (100%) | 0 (0%) | 0 (0%) |
| Antibiotic | cOR | 95% CI | p-Value | |
|---|---|---|---|---|
| Levofloxacin ** | Age group | |||
| 18–24 years | Ref. | |||
| 25–34 years | 0.03 | 0.001–1.05 | 0.053 | |
| 34–45 years | 0.33 | 0.14–8.18 | 0.5 | |
| Area of residence | ||||
| Rural | Ref. | |||
| Urban | 0.29 | 0.03–2.36 | 0.25 | |
| Moxifloxacin * | Age group | |||
| 18–24 years | Ref. | |||
| 25–34 years | 0.19 | 0.03–1.28 | 0.09 | |
| 34–45 years | 0.22 | 0.02–2.69 | 0.24 | |
| Area of residence | ||||
| Rural | Ref. | |||
| Urban | 0.77 | 0.14–4.42 | 0.77 | |
| Erythromycin * | Age group | |||
| 18–24 years | N/A. | |||
| 25–34 years | Ref. | |||
| 34–45 years | 5.2 | 1.05–26.2 | 0.043 | |
| Area of residence | ||||
| Rural | Ref. | |||
| Urban | 0.43 | 0.1–1.85 | 0.26 | |
| Clindamycin * | Age group | |||
| 18–24 years | Ref. | |||
| 25–34 years | 0.25 | 0.3–2.04 | 0.2 | |
| 34–45 years | 0.5 | 0.05–5.03 | 0.56 | |
| Area of residence | ||||
| Rural | Ref. | |||
| Urban | 0.6 | 0.22–1.62 | 0.32 | |
| Tetracycline * | Age group | |||
| 18–24 years | Ref. | |||
| 25–34 years | 1.3 | 0.25–6.69 | 0.75 | |
| 34–45 years | 2.27 | 0.28–18.27 | 0.44 | |
| Area of residence | ||||
| Rural | Ref. | |||
| Urban | 0.16 | 0.02–1.24 | 0.08 | |
| Rifampicin *** | Age group | |||
| 18–24 years | N/A. | |||
| 25–34 years | Ref. | |||
| 34–45 years | 0.74 | 0.15–3.69 | 0.71 | |
| Area of residence | ||||
| Rural | Ref. | |||
| Urban | 0.61 | 0.14–2.74 | 0.52 | |
Disclaimer/Publisher’s Note: The statements, opinions and data contained in all publications are solely those of the individual author(s) and contributor(s) and not of MDPI and/or the editor(s). MDPI and/or the editor(s) disclaim responsibility for any injury to people or property resulting from any ideas, methods, instructions or products referred to in the content. |
© 2024 by the authors. Licensee MDPI, Basel, Switzerland. This article is an open access article distributed under the terms and conditions of the Creative Commons Attribution (CC BY) license (https://creativecommons.org/licenses/by/4.0/).
Share and Cite
Marc, C.C.; Susan, M.; Sprintar, S.A.; Licker, M.; Oatis, D.A.; Marti, D.T.; Susan, R.; Nicolescu, L.C.; Mihu, A.G.; Olariu, T.R.; et al. Prevalence and Antibiotic Resistance of Streptococcus agalactiae in Women of Childbearing Age Presenting Urinary Tract Infections from Western Romania. Life 2024, 14, 1476. https://doi.org/10.3390/life14111476
Marc CC, Susan M, Sprintar SA, Licker M, Oatis DA, Marti DT, Susan R, Nicolescu LC, Mihu AG, Olariu TR, et al. Prevalence and Antibiotic Resistance of Streptococcus agalactiae in Women of Childbearing Age Presenting Urinary Tract Infections from Western Romania. Life. 2024; 14(11):1476. https://doi.org/10.3390/life14111476
Chicago/Turabian StyleMarc, Constantin Catalin, Monica Susan, Sergiu Adrian Sprintar, Monica Licker, Daniela Adriana Oatis, Daniela Teodora Marti, Razvan Susan, Laura Corina Nicolescu, Alin Gabriel Mihu, Tudor Rares Olariu, and et al. 2024. "Prevalence and Antibiotic Resistance of Streptococcus agalactiae in Women of Childbearing Age Presenting Urinary Tract Infections from Western Romania" Life 14, no. 11: 1476. https://doi.org/10.3390/life14111476
APA StyleMarc, C. C., Susan, M., Sprintar, S. A., Licker, M., Oatis, D. A., Marti, D. T., Susan, R., Nicolescu, L. C., Mihu, A. G., Olariu, T. R., & Muntean, D. (2024). Prevalence and Antibiotic Resistance of Streptococcus agalactiae in Women of Childbearing Age Presenting Urinary Tract Infections from Western Romania. Life, 14(11), 1476. https://doi.org/10.3390/life14111476

